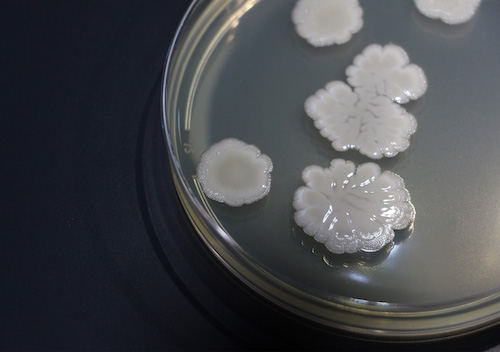
Koppert Brasil confirma presença no Dia de Campo Lar 2026, no Oeste do Paraná

Koppert Brasil confirma presença no Dia de Campo Lar 2026, no Oeste do Paraná
Líder global em soluções biológicas, a empresa apresenta soluções biológicas inovadoras de seu portfólio em um estande orientado à experiência técnica dos visitantes

A Koppert Brasil confirma presença no Dia de Campo Lar 2026, que acontece de 14 a 16 de janeiro, na região de Medianeira (PR). O evento é uma referência no estado e considerado uma vitrine para o agronegócio paranaense, reunindo produtores cooperados, consultores, técnicos, investidores e órgãos de imprensa especializada.
Líder global em bioinsumos, a Koppert traz soluções inovadoras de alto desempenho em controle biológico, manejo integrado de pragas e doenças, com foco especial nas culturas de soja e milho.
Com um estande orientado à experiência técnica, a empresa apresenta ainda o ecossistema do Sistema Integrado Koppert (SIK) para elevar a eficiência operacional, estabilidade produtiva e retorno econômico no campo.
Destaques do estande
Um dos destaques apresentados este ano é o Caravan® (Bacillus pumilus), biodefensivo à base de bactérias benéficas de alta performance utilizado para fortalecer o arranque e a consistência produtiva da soja ao longo do ciclo, como parte das estratégias e práticas do manejo integrado de doenças (MID).
Outra solução apresentada, desta vez para o cultivo de milho, é o Octane® (Isaria fumosorosea CEPA ESALQ 1296), um bioinseticida exclusivo com foco no manejo da cigarrinha-do-milho (Dalbulus maidis). O produto pode ser aplicado em diferentes estágios de desenvolvimento da praga e possui ação rápida e duradoura.
Caravan® e Octane® fazem parte do Sistema Integrado Koppert (SIK), uma abordagem que oferece soluções inovadoras, incluindo monitoramento, inoculantes, bioativadores, micro e macrobiológicos, além de ferramentas tecnológicas como drones – uma parceria com a Natutec® by Koppert – e aplicativos para compatibilidade de produtos. *Os produtos são vendidos separadamente.
Para ambos os produtos, a equipe técnica da Koppert apresentará protocolos de posicionamento por janela fenológica, trilhas de compatibilidade e posicionamento de qualidade para maximizar a eficiência.
“O produtor busca previsibilidade. Nosso papel é transformar biológicos em produtividade, com posicionamento técnico, qualidade de aplicação e tomada de decisão orientada por dados. No Oeste do Paraná, vamos mostrar como nosso portfólio eleva a resiliência dos sistemas produtivos e entrega resultados, nos campos de soja e nos milharais”, afirma Marcelino Brito, Gerente de Desenvolvimento de Mercado da Koppert Brasil.






